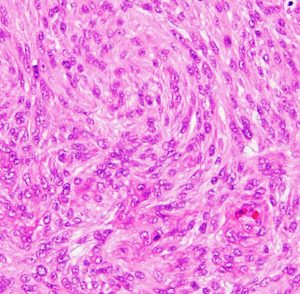

髄膜腫 meningioma
脳腫瘍では最も多い良性の腫瘍です
- 頭痛やたまたま頭をぶつけた時などに,CTやMRIをとって偶然に見つかることが多いです
- 全く症状がない無症候性髄膜種は最近たくさん発見されるようになってきました
- 人口の0.2-1%に見つかります,200-500人に一人,すごく多いです
- 高齢者ほど多くなります
- 症状のない大部分の髄膜種は治療の必要はなくてほっておいていいものです
- 多くは,ほっといても大きくならないし症状も出ません
- 脳ドックで見つかって脳腫瘍だと言われてもびっくりしないで安易に手術を受けないことにしましょう
- 下のMRIは66歳の女性に脳ドックで偶然見つかった髄膜腫です.左の写真は1995年,右は2005年です。10年間で全く大きくなっていません
おおまかなこと
- 髄膜腫は脳を包んでいる髄膜という膜から発生する良性腫瘍で脳の表面にできます
- 中年以降の女性に多いです
- 他の場所へは転移しないし,良性の経過をとります
- 治療は開頭手術摘出で,取れれば治ります
- 悪性かどうかは画像を見るか,ちょっと経過を見ればだいたい判断できます
- グレード2は非定型(異型性)髄膜腫 atypical meningioma といいます
- 非定型髄膜腫は再発しやすいもので頻度もやや高い (5-8%) ので要注意
- 病理診断をしっかりしないで,再発を繰り返し命をなくす患者さんはいます
- 悪性の経過をたどるのはとても少なくて2%ほどです
- グレード3退形成性髄膜腫は肉腫(ガン)ですが,ものすごく稀 (1%以下) です
- 再発を予測するために,手術後の病理診断がでたらミブワン(後述)の値を聞きましょう
- 頭蓋内のさまざまな部位にできて,発生する場所によって治療の難しさが違います
- 髄膜腫をもっている女性は乳がんになりやすい体質です,乳がん検診をしておきましょう
症状は
- 症状がなくて発見されるものが多いです
- 脳の外側の膜(髄膜)に発生して脳や神経を圧迫します
- かなり大きくならないと症状がでないものが多いです
- 大きくなると脳を圧迫して、頭痛,運動麻痺,歩く時にふらつく,けいれん発作(てんかん)などをおこします
- 小さくても脳神経を圧迫すると,目が見づらい(視力視野障害),ものが二重にみえる(複視),顔がしびれて痛い(三叉神経障害),片耳が聞こえない(聴力障害)などの症状がでます
- すごく大きいものでも軽い症状(頭痛,物忘れが多い)で経過するものもあります
- 髄膜腫のできる場所と症状には関連があります
- 前頭部の大きなものでは認知症がでることがあります
- 穹窿部髄膜腫は相当大きくならないと症状が出ず,てんかんで発症することが多いです
- 傍矢状洞髄膜腫は,下肢からはじまるけいれんや足の麻痺を生じます
- 鞍結節部髄膜腫は,視力視野障害で発症します
- 斜台錐体骨や海綿静脈洞部髄膜腫は,物が2重に見えるようになります(眼球運動障害)
- 小脳橋角部(錐体骨縁)髄膜腫では聴力低下がでます
- 錐体骨尖部髄膜腫は,顔面の痛みやしびれをだします(三叉神経障害)
検査は
- 診断は,CTやMRIという簡単な検査でかなり正確にできます
- MRI T1強調画像やT2強調像で,さまざまな信号を呈します(白っぽいことも灰色にみえることもあるということです)
- ガドリニウム造影剤で,髄膜腫がはっきりみえます(コントラストがついて白く見えます)
- T2強調やフレア画像では,腫瘍周囲に強い脳浮腫(脳が腫れる)があることも多いです
- CTでみえる限局性の骨肥厚(骨が厚くなる)は髄膜腫に特徴的な所見です
- 診断のために,脳血管造影(DSA,カテーテル検査)は必要ありません
- 手術を前提にしても,ほとんどの例でカテーテルを動脈に入れる血管撮影は必要ありません
- もし開頭手術で髄膜腫を摘出する前に,血液の流れを見て塞栓術をしないと手術にリスクがあるということを言われても安易に受けない方がいいでしょう
- カテーテルを用いる血管撮影は,脳梗塞などのリスクもありお金(医療費)もかかります
左は,造影剤を使ったガドリニウム増強MRIです。腫瘍が白く丸く見えます。右はフレア画像で,腫瘍の周囲の脳浮腫(脳のはれ)です。左前頭葉が,かなり強くはれています。この腫瘍は小さいのですが,脳のはれが強すぎるので手術摘出したほうがいいです。浮腫が悪化すると,てんかん発作や認知機能低下がでる可能性があります。
どうしたらいいのか,治療はすべきか
- 経過を見ていると,ゆっくりと大きくなることもあるけど,大きくならないことも多いです(このはっきりした確率は不明です)
- 多数例の報告では,偶然発見された髄膜腫の治療が必要となるのは10%程度とも言われます
- 特に,お年寄りの髄膜種は全く大きくならないことが多いので様子をみます
- 少し大きくなってもまた増大が止まることがあります (growth arrest)
- でも,若い人ではたとえ小さくても慎重に判断してから,経過を観察した方がよいでしょう
- 20代までに見つかった髄膜腫は摘出した方がいいです,それ以降の年代は判断が難しい
- CTで腫瘍の石灰化がある,T2強調画像で低信号(黒っぽい)ものは大きくならない傾向があります
- 周辺の脳が腫れている脳浮腫がめだつ時は,症状がなくても手術で摘出した方がいいこともあります
治療は
- 症状が悪化しそうな腫瘍は開頭手術でとる必要がありますが,完全にとってしまえば治る病気で再発の心配はいりません
- 手術が第一選択肢で,開頭手術で完全摘出してしまえば治る腫瘍です
- それぞれの脳神経外科医によってかなり考え方が違います
- 手術が必要と言われてもそのまま受け取らないで,なぜ必要かをしっかり説明していただくことが大切です
- 不安ならば,手術を受けるかどうかはセカンドオピニオンを聞いてから決めましょう
- 髄膜腫は脳の中にできる腫瘍と違って脳を切らなくてもとることができますので,慎重な手術さえすれば後遺症が残ることは少ないです
- 脳外科研修医の先生でも手術できる簡単なものから,ベテランがしても命が懸かるようなものまであります
- 頭蓋底にできたときや,周りの神経や血管との癒着が強い場合は、完全に摘りきれない場合がありますし,その場合は数年~10年後に再手術となることもあります
- 薬(制がん剤)は効きませんが,放射線治療は有効といえます
- 放射線外科治療 (SRS ガンマナイフなど)より,定位分割放射線治療 (IMRT, 3D-CRTの方が有効性が高いことに注意です
- かなり手術のリスクの高い例や手術後の障害(後遺症)が予測される髄膜腫は,手術で無理せず部分摘出して,残った腫瘍に放射線治療をするという考えが一般的になってきました
- ですから,無理な超時間かかる危険な頭蓋底手術などはしないという方向にあります
- 髄膜腫に詳しい医師に早めに相談しましょう
経過を見たらどうなるか
Herscovici Z: Natural history of conservatively treated meningiomas. Neurology 63, 2004
252人の髄膜腫の患者さんを5年程度観察すると,3分の1くらいの患者さんで腫瘍が増大して,3分の2の患者さんでは腫瘍サイズが変わらないとのことです。大きくなっても年に3mmかそれ以下の増殖速度で,ほとんどが無症候性で手術の必要はありませんでした。その後も大規模な報告がありますが大きな違いはありません。まずしばらく経過を見てから治療するかどうかの判断が勧められます。しかし,髄膜腫のできる場所によっては経過観察をしない方がいいものもあります。たとえば視神経近傍の髄膜腫などです。高度な専門的な判断が必要です。1年に3mm大きくなるというのは早い方です。
経過観察の判断は
Islim AI:A prognostic model to personalize monitoring regimes for patients with incidental asymptomatic meningiomas. Neuro Oncol. 2020
英国からの報告です。441人の髄膜腫の患者さんが55ヶ月,約6年ほど追跡されました。44例 10%で進行 progressionがありました,逆に359人ではなかったとの結果です。手術などの治療を受けたのは44人で,発見時6人,progressionのため20人,progressionなく手術18人でした。57人の患者さんがこの間に亡くなったのですが,それは高年齢層で髄膜腫とは関連のない疾患でした。経過を5年間みて,髄膜腫ではない他の疾患で患者さんが死亡する確率は,髄膜腫の手術治療などが必要になる確率の15倍だそうです。髄膜腫のリスクは,経過を見ると増大するもの,腫瘍がT2高信号となるもの(増大が早い),周囲脳の信号変化(周囲の脳浮腫と腫瘍の脳浸潤),重要な神経血管構造に近接する位置の4つの要素で決められるとの結果です。
進行 progressionの定義は,髄膜腫の治療リスクが高まる状況です。すなわち,症状の悪化,死亡する原因となる状況,脳浮腫と脳浸潤の増悪,静脈洞内への浸潤が新たに生じる,体積が10cm3を超えてくるなどの変化をいいます。
この20年くらいの間の文献をみても傾向はあまり変わらず,髄膜腫は発見されても治療が必要となる確率はかなり低いと言えます
放射線治療は有効です,ガンマナイフだけではない
- 小さなものに対しては有効だと考えたほうがいいでしょう
- まず第一に,ガンマナイフだけが有効というわけではなく,分割放射線治療の方が使用頻度が高いことを知っておいてください
- 摘出できない場所にできたものには定位放射線治療(リニアック、ガンマナイフ,サイバーナイフ,ノバリス,トモテラピー)を用います
- どの装置をどのように用いるのが適切か,判断できる医師に相談します
- 60%くらいしかコントロールできないという意見も,90%効くという報告もあります
- グレード3でなければ,IMRTもしくは3D-conformal RTを用いて54グレイ30分割(1回線量1.8Gy)の分割放射線治療で95%ほどの制御率が期待できます
- かなり限局性で境界が明瞭,小さななものには放射線外科治療 SRS (ガンマナイフ,サイバーナイフ )を用います
- でもそれは髄膜腫の大きさに比例することが多いです,1 cmくらいの小さなのものなら確実性は高いでしょう,5 cmも広がってしまうとコントロールは難しい
- 髄膜腫の場所によって応用するかどうかが決まります
- 海綿静脈洞髄膜腫は最初から手術しないで定位放射線治療が選択されます
- 視神経鞘髄膜腫は視力の良いうちに,手術はしないで定位分割放射線治療 50.4Gy/28frを行えば視力が守れるということもあります
- グレード2 非定型髄膜腫には有効性はあるのですが,グレード3の悪性髄膜腫を制御することはほとんどできません
- グレード2で手術で全部取れなかった時には,手術後に放射線治療をします
- 運動野に接する髄膜腫にガンマナイフ治療すると,治りにくいてんかん発作を生じることがあります
(゜Д゜) ! 髄膜腫専門外来??
最近患者さんから,ネット検索で,髄膜腫専門家がいる「髄膜腫外来」がある,という話を聞きます。髄膜腫の専門家というのは存在しないので気をつけてください。髄膜腫は頻度の高い脳腫瘍で手術が必要なことが多いので,手術患者さんを集めるための宣伝の道具として,専門外来が名乗られて利用されているきらいがあります。髄膜腫外来と書いてあるところには逆に行かない方がいいかもしれません。手術治療をまず勧める脳外科医の先生は?です。
典型的な髄膜腫
この髄膜腫は中程度の大きさのものです。円蓋部髄膜種という最も多い最も手術の簡単なタイプです。麻痺や失語症やてんかんなどの症状はありません。とても美しくて若い女性の髄膜腫でしたが,子供に遺伝はしませんし,癌などと違ってタバコなどこれといった原因がなくて発生するものです。
MRIでの髄膜腫の見え方は撮影の仕方によっていろいろです。左からT1強調画像,T2強調画像,フレア画像といいます。腫瘍の横に小さく白い領域がありますが,これは脳の腫れた部分で脳浮腫といいます。髄膜腫があると周囲に脳浮腫が生じることがあります。
最も見やすいのが,ガドリニウム造影剤を注射して撮影するものです。一般的に髄膜腫は造影剤で白く映し出されます。この腫瘍は左脳側にあります。MRIの軸面という輪切りの写真では左右が逆になりますから注意してください。脳を下から見た図になっています。MRIはいろいろな方向から腫瘍を見ることができますが,右は冠状断という正面から見た図です。よく見ると腫瘍の上と下のはじっこに線状に糸を引いたように造影される部分があります。これをテールサイン(しっぽのサイン)といいます。腫瘍が硬膜に沿って延びている可能性があることを示しています。
手術後のMRIです。腫瘍は全部取れていて後遺症もありません。圧迫されて変形していた脳はきれいに元に戻っていますし脳浮腫も消えました。一般的に若い人の脳ほどきれいに元に戻ります。注意しなければならないのは,少しでも取り残した場合には,何年か後に10%-20%くらいで再発があることです。もちろん完全に取れた時の再発はほとんどありません。
手術後の再発は?
手術でとり切れたと思っても再発することがありますし,手術で残った腫瘍が何年も全く大きくなって来ないこともあります。手術で完全摘出したといわれても,10年くらい見ると数%で再発する可能性があると思った方がいいかもしれません。
再発を予想するのには,病理の所見を見ます。 上の写真がMIB-1(ミブワン)というのを染色したものです。細胞の核が青く染まっているのは細胞が増えない。濃い茶色に染まっているのは細胞が増えようとしていることを示しています。ですから,このミブが多く染まっていると再発し易い髄膜腫といえます。この写真の腫瘍は5%くらい染まっているので,再発するあるいは残っている髄膜腫が大きくなる確率が高い(非定型髄膜腫グレード2)と判断します。正確には,グレード2 は強拡で4個以上の核分裂像があると定義されます。
悪性の髄膜腫の頻度は? 2015年米国の統計
グレード1 94.6% とれれば治る
グレード2 4.2% 再発率が高い
グレード3 1.2% 本当の悪性,肉腫
脳浮腫(脳のはれ)
- 髄膜腫が発見されると「まわりの脳が腫れている」と説明されることがあります
- これを腫瘍周辺脳浮腫 peritumoral brain edema といいます
- 髄膜腫の20-30%くらいでみられます
- 脳浮腫が強いと,はれている部分の脳の機能が落ちます
- 認知症,感覚障害,運動麻痺,失語症,てんかん発作などの症状が出やすくなります
- 髄膜腫が全部とれると,この脳の腫れも消えます
- 腫瘍血管が増える時にVEGFが産生されるために,脳の細血管の透過性が亢進して,血液の中の血漿成分が脳組織の中に漏れ出ることが原因です
髄膜腫に関する澤村へのご相談はこちらから(ここをクリック)
単純なお問い合わせはメールでします。画像などを見るセカンドオピニオンも受け付けています。
いろいろな髄膜腫を見たい方はここをクリック
ここから下は難しいです
メニンジオーマ・ギャラリー

8年間の観察で大きくならなかった髄膜種(左1996年,右2004年)
びっくりするくらい大きい髄膜腫でも経過を見てよいこともあります
半年で大きくなったグレード2の非定型髄膜腫
50代男性に無症状の髄膜腫が見つかりました。右側は6ヶ月後のMRIで,半年の経過でかなり早く大きくなりました。でもこのようなものは稀で,ほとんどの髄膜腫は半年くらいでは目立って大きくなりません。この患者さんのMIB-1は8%で,グレード2非定型髄膜腫でした。こんなものでも全部取れれば治るので心配ありません。
15年間でゆっくり大きくなったグレード1の良性髄膜腫
1998年にテントにごく小さな髄膜腫が発見されました。左は,その7年後のMRIで少し大きくなりました。右は,そのさらに8年後のMRIでまたゆっくり大きくなりました。グレード1の髄膜腫の15年間の経過観察です。ですから,経過観察で腫瘍が大きくなっても慌てないで,さらに経過観察してもいいこともあります。
手術後の合併症としての感染
- 髄膜腫は,脳の膜である硬膜や頭蓋骨に腫瘍が浸潤(細胞がしみ込む)することがあります
- ですから,腫瘍と一緒に,硬膜や頭蓋骨を取り除くことがあります
- そうすると,欠損した硬膜や頭蓋骨を補填(他のものに置き換える)しなければなりません
- 硬膜の場合は,人工硬膜(ゴアッテックス,シームデュラ)などを用いたり,大腿筋膜,頭蓋骨膜を使ったりします。
- 人工硬膜は異物ですから,細菌感染の原因になることがあります
- このこの感染は術後数週間で生じることもありますが,術後数年でおこることもあります
- とくにゴアテックスの感染はたくさんみました
- ゴアテックスに感染が生じた場合にはそれを除去しないと何度も感染を繰り返します
- 頭皮や骨弁の感染と間違えてゴアッテックスを取り除かないで感染を繰り返すこともしばしばです
- 髄膜炎がなくて人工硬膜が感染した場合には単にそれと骨弁を取り除くだけでいいのですが,硬膜がないことを心配してまた新たな人工硬膜をおいてくるとそれにまた感染します
- シームデュラも異物です。
- 私自身は大腿筋膜を使ったことはありませんし,大腿部の傷跡がつらいことになります。
- 常に,開頭部やその周辺から採取できる頭蓋骨膜 pericranium(異物ではない自家組織)で硬膜の欠損部を覆っています,相当に大きな硬膜欠損もこれで対応できます。
- 頭蓋骨の補填には,かつてはアクリルリジンがもっともよく用いられましたが感染が多いものでした
- とくに鼻腔,耳腔の近くに人工骨をおくと感染を誘発します
- チタンメッシュ,セラミック/ハイドロキシアパタイト(アパセラム,セラタイト),ポリエチレン(クラニオフィット)なども,人工頭蓋骨ですから「異物」です
- 小さな骨欠損ではバイオペックスという材料が用いられます
- チタンメッシュは数年で皮膚に取り込まれて毛根を侵し,皮膚が菲薄化するという遅発性合併症のリスクがあります
- 髄膜腫の浸潤している骨弁を捨てないで,手術中に熱処理して髄膜腫の細胞を死滅させて,元に戻すという方法が有用です
とにかく異物を残してこないということが術後感染症を減少させるコツです
自己輸血
- 自己輸血には,術直前採血・血液希釈法(希釈法)、出血回収法(回収法)、貯血式自己血輸血法(貯血法)の3つの方法があります
- 髄膜腫の手術では,貯血法と希釈法が利用されます
- 貯血法というのは,手術数週間前から2ヶ月前くらいに1回か2回採血して、全血を冷凍保損じておいて手術出血時に使う方法です
- 希釈法とは,手術室で全身麻酔が開始されたすぐ後に、400 ml -1,000 ml の自己血を採血して同量の輸液して体内の血液を薄める方法で,手術中に必用に応じてこの血液をもどし輸血します
実際に髄膜腫の手術で自己輸血が必用となることはほとんどありません,それが必用なのは出血の多い手術をしてしまうからです(外科医の技術が足りない)
もし行うとしても希釈法で麻酔導入時の採血で十分です,手術入院の前に自己血採血をする必用はありません
髄膜腫の病理はここをクリック
頭の中にたくさんの髄膜腫ができる病気
髄膜腫症 meningiomatosis は別のページですからここをクリック
これから下は専門的記述です
病因・病理
- 髄膜腫は髄膜 meningesより発生した腫瘍という意味で用いられていますが,組織学的には,くも膜細胞,線維芽細胞あるいは髄膜血管組織より発生するものが含まれるので,WHO分類の亜型に見られるような様々な組織像があります
- 髄膜腫は,RNA polymerase IIをコードするPOLR2A遺伝子異常などよって発生しますが,いろいろな遺伝関与があります
- 発生頻度は原発性脳腫瘍の20%ほどで,神経膠腫と共に頻度の高い腫瘍といえます
- 好発年齢は40歳代,50歳代で女性に多いです
- 女性ホルモン(黄体ホルモン製剤など)の投与が発生リスクとなることは証明されています
- 近年増加の傾向にあるのは,MRIの普及と伴に無症候性髄膜腫の発見頻度が飛躍的に増加したためです
- 発生部位としては傍矢状洞部,円蓋部,大脳鎌,蝶形骨縁,鞍結節部,嗅窩,テント,小脳橋角部,中頭蓋窩などがあり,たとえば前頭円蓋部髄膜腫のごとく,それぞれの部位に髄膜腫という語をつけて診断名として用います
- 傍矢状洞部,円蓋部,大脳鎌を合わせると髄膜腫の半分以上を占めます
- 病理診断で最も特徴的な組織学的構造物は渦巻形成 whole formationで,石灰沈着である砂粒体 psammoma bodyの存在も診断の手がかりとなります
- 1つの腫瘍の中に先にあげたタイプが混在して認められることも多いです
- ほとんどの例が良性で孤発性ですが,髄膜腫の2%程度に悪性髄膜腫 malignant meningiomaとされるものが存在します
- 神経線維腫症2型(NF-2)は多発性髄膜腫(髄膜腫症 meningiomatosis)を生じることがあります
WHO分類 (2007年)
- Grade I:meningothlial, fibrous (fibroblastic), transitional (mixed), psammomatous, angiomatous, microcystic, secretory, lymphoplasmacyte-rich, and metaplastic meningiomas
- Grade II : atypical meningioma (mitotic index > 4 in1 high-power fields), clear cell meningioma, chordoid meningioma
- Grade III : anaplastic (malignant) meningioma (mitotic index > 20), rhabdoid meningioma, papillary meningioma
改正された注意点:古くからて脳への浸潤がある髄膜腫は再発率が高いことが知られていました (Perry 1999)。新しい定義では,Brain invasion by a meningioma is now an independent criterion for WHO grade II. 組織型に関わらず,脳への浸潤がある髄膜腫はgrade II です。この分類では再発率は高いものの,患者の死亡割合と関連するものではないことに注意する必要があります。高い増殖能を有する髄膜腫は mitotic index (MIB-1で代用) によってgradingを決めます。
逆に,grade IIIの髄膜腫は肉腫と考えられ死亡割合(腫瘍死)は高いです。grade III 髄膜腫は脳への浸潤や脳血管への癒着浸潤,頭蓋骨,筋軟部組織,頭皮に深く浸潤して再燃を繰り返します。また隣接する硬膜などの原発巣近傍再燃のみならず,広範に硬膜下腔へ転移したり,髄液播種したり,肺などへの他臓器転移もあります。この病理診断を得た場合には,ガン(肉腫)であることを患者に説明して,可能であれば再手術にて根治的郭清手術を行なうことを検討しなければなりません。少なくともgrade IIとIII(退形成性髄膜腫,ラブドイド髄膜腫,乳頭状髄膜腫)の髄膜腫の組織型は記憶に留めておいた方がよいでしょう。多発性の頭蓋脊柱管内転移再発をきたした場合には治療方法がありません。
2017年時点ではDNA methylation-based meningioma classificationという分類の研究が進行していますが,臨床的に応用されるのは2023年以降でしょう。
グレード2から3へと悪性化する
もともと巨大な傍矢状洞 非定型髄膜腫 WHO grade 2で全摘出しました。左側は8年後の再発で摘出。中央は9年後の再発で摘出。右側は11年度の再発で側頭穹窿部にも転移しています。
左は13年後の前頭先端部再発。中央は15年後の蝶形骨縁再発。右は17年後の前頭蓋底と蝶形骨縁再発です。その都度,摘出しています。

18年後には中頭蓋底から蝶形骨洞方向へと浸潤して大きな再発となりました。悪性度が高くなると頭蓋内の至る所へ転移再発します。
このような髄膜腫は放射線治療にも抵抗性で,摘出と放射線外科治療を何度もなんども繰り返している内に制御がきかなくなります。
病理像です。左側は初発時のグレード2の髄膜腫。右側は遠隔転移をするようになった頃のものです。グレード2という病理診断でしたが,ほぼグレード3です。核異型性が高く,分裂像が散見され壊死を伴います。MIB-1標識率は25%に達しました。肉腫ともいえるものです。
髄膜腫の発生原因
Clark VE, et al.: Recurrent somatic mutations in POLR2A define a distinct subset of meningiomas. Nature Genetics 48, 2016
Yale大学からの報告です。RNA polymerase IIというとても重要な遺伝子に異常があって髄膜腫が発生するという,ある意味衝撃的な発表です。775例の髄膜腫を調べて,RNA polymerase IIをコードするPOLR2Aに,recurrent somatic p.Gln403Lys or p.Leu438_His439del mutationsを発見したとのことです。この遺伝子がハイジャックされることで,髄膜の発生に関わるWNT6 and ZIC1/ZIC4の制御異常が生じます。既知のNF2, SMARCB1, TRAF7, KLF4, AKT1, PIK3CA, SMOに加えて,AKT3, PIK3R1, PRKAR1A, SUFUにも変異が認められるとの報告です。
髄膜腫と間違えやすい SFT (へマンジオペリサイトーマ,孤在線維性腫瘍)

髄膜腫と間違えやすい腫瘍はたくさんあります。でも時々本当に手術前画像診断で間違うのが,SFTです。SFTは硬膜から発生して不整形の形をしていることが多いので,グレード2の非定型髄膜腫と間違うのですが。悪性度があるので要注意です。
文献情報
髄膜腫がある女性は,乳がんに10倍なりやすい
The Association Between Meningioma and Breast Cancer: A Systematic Review and Meta-analysis. JAMA Netw Open 2023
乳がんと髄膜腫の両方を有する2238人の女性のメタ解析からの結果です。髄膜腫を有する女性は乳がんになりやすいのは古くから知られていました。その頻度が10倍だという報告です。
髄膜腫の術後予後
Rogers CL: Low-risk meningioma: Initial outcomes from NRG Oncology/RTOG 0539. Neuro Oncol 2023
グレード1の髄膜腫で全摘出あるいは亜全摘出を受けた60例の患者さんが経過観察(中央値9.1年)されました。無増悪生存割合は,3年で91%,5年で89%,10年で85%でした。4例が再発時にグレード2となり1例がグレード3となっていました。かなり大雑把に考えて,術後再発あるいは再燃は10%程度ということです。
グレード2と3の髄膜腫への放射線治療
Radiation therapy for atypical and anaplastic meningiomas: an overview of current results and controversial issues. Neurusurg Rev 2022
現時点での疑問点は,全摘出できたグレード2 非定型髄膜腫に放射線治療をするべきかそれともまず経過観察するべきかということだそうです。これまでは,全摘出できれば,経過観察というのが標準的な考え方です。グレード2への術後照射のタイミングについてのコンセンサスはないというのが結論です。
髄膜腫の患者さんにホルモン療法を行うことに注意勧告
ヨーロッパのPRACからの警告です。ノメゲストロール (nomegestrol:経口避妊薬、更年期ホルモン療法、および婦人科疾患の治療に使用されるプロゲスチン薬),クロルマジノン(chlormadinone:無月経,月経周期異常に使用される男性ホルモンを抑制する薬剤)などの使用量を多くすると髄膜腫の進行が生じるそうです。これらは特殊な薬剤ですし,低用量のホルモン療法は問題となりません。
ペムブロリズマブ pembrolizumabが悪性度のある髄膜腫の成長を遅らせるかもしれない
Brastianos PK: Phase 2 study of pembrolizumab in patients with recurrent and residual high-grade meningiomas, Nature Communications, 2022
ペムブロリズマブは免疫チェックポイント阻害剤です。臨床第2相試験で,25例の患者さんに投与されました。6ヶ月時点で半数の患者さんで腫瘍増大が生じませんでした。でも,少数例なので今後のより大きな臨床研究を待たなければなりません。
髄膜腫の予後をしめす新たな分子分類
Nassiri F: A clinically applicable integrative molecular classification of meningiomas. Nature 2021
分子レベルで分類すると4グループとなり,immunogenic, benign NF2 wild-type, hypermetabolic, proliferativeと命名されています。日本語に訳すと誤解が生まれるので訳しません。immunogenic group MG1 が悪性度が最も高いもので,anaplastic meningiomaの臨床像に近いようです。しかし,immunogenicなどこの命名の理由づけに関しては臨床医は理解しづらいものがあります。実際の臨床の場で応用されるのには,免疫組織染色レベルでこれらの4グループが簡単に鑑別診断できるようにならなければならないのでまだ先の話かもしれません。
意外に多い術後感染
Analysis of meningioma patient data from the US-based The Nationwide Readmissions Database (NRD)による2020年の報告です。2010年から14年までに26,034人が髄膜腫の手術を受け,術後90日時点で再入院になった患者さんは3,436名でした。術後感染が最も多い原因でした。6人に一人が術後3ヶ月以内に短期間といえど再入院になるというのは驚きです。日本は術後の入院期間が米国よりかなり長く,抗生物質の使用頻度が高いので,こんな数字にはなりませんが,感染症が意外に多いということは知っておく必要があるでしょう。
男性ホルモンを抑制すると髄膜腫のリスクが高まる
2019年 The European Medicines Agency (EMA)からのレポートです。抗アンドロゲン(男性ホルモン)薬のシプロテロン酢酸塩を使用すると髄膜腫の発生/再発リスクが高まるそうです。シプロテロン cyproteroneは前立腺癌やニキビの治療に使用された男性ホルモンを抑制する薬剤です。日本では販売が中止されています。女性ホルモンの投与で髄膜腫のリスクが高まるということなど考えあわせれば,グレード2の髄膜腫や手術後に残っている髄膜腫を持っている患者さんには,女性ホルモンを投与したり男性ホルモンを抑制するホルモン治療はしない方がいいと考えられます。
再発した髄膜腫の手術成績
Magill ST: Surgical outcomes after reoperation for recurrent skull base meningiomas. J Neurosurg 2019
サンフランシスコ UCSFからの再発髄膜腫の手術成績と合併症の報告です。頭蓋底とテント下の難しい髄膜腫は除外してあり,再手術としては簡単な部類の髄膜腫の成績です。
67人の患者さんのうちグレード1が22%,グレード2が51%,グレード3が27% (18人)でした。手術を重ねることによって腫瘍のグレードが上昇した例は22%でした。32人 (48%)の患者さんで手術合併症が生じました。さらに,約半数 (54%)で,手術合併症に対する外科処置が必要となりました。合併症は,神経脱落症状 14%,感染と創部離開など 14%,髄液漏 9%などです。再手術からの生存割合は,2年で91%,5年で69%,10年で50%でした。手術前に認知機能の低下がある患者さんと頭部の中央正中に髄膜腫がある場合で,合併症発生率が高かったそうです。髄膜腫の再手術は,高い率で合併症が生じると結論されています。
全摘出したグレード2の髄膜腫,再増大したグレード1の髄膜腫は54グレイの分割照射でほとんど制御できる
Rogers L: Intermediate-risk meningioma: initial outcomes from NRG Oncology RTOG 0539. J Neurosurg. 2018
グレード2 非定型髄膜腫で全摘出できたもの,グレード1の髄膜腫で術後再発した48例の髄膜腫が対象の試験です。IMRTもしくは3D-conformal RTを用いて54グレイ30分割(1回線量1.8Gy)の放射線治療がされました。全摘後のグレード1ではtumor bedがGTVで,照射野のmarginは8-15mmです。3年無増悪是依存割合 PFSは,93.8%でした。3年時点で局所制御できなかったものは,4%でした。96%で局所制御できたということです。
放射線治療後に再発した髄膜腫への陽子線と重粒子線治療
El Shafie RA, et al.: Evaluation of particle radiotherapy for the re-irradiation of recurrent intracranial meningioma.Radiat Oncol 2018
通常の放射線治療後の再発髄膜腫(グレード1が11例,グレード2が25例,グレード3が5例)に対して,陽子線8例,炭素線34例の治療がされました。24ヶ月後に腫瘍増大がなかった例 PFS が56%でした。6割程度の患者さんに利益がありそうです。
非定型髄膜腫への放射線治療
Wang C, et al.: Overall survival benefit associated with adjuvant radiotherapy in WHO grade II meningioma. Neuro Oncol. 2017
グレード2髄膜腫と診断された2,515例の解析です。当たり前のような結果ですが,全摘出 gross total removalできた患者さんには放射線治療を加えても生存期間の延長はありませんでしたが,亜全摘出 subtotal removal では術後に放射線治療をしたほうが生存期間が有意に長かったとの結論です。
小児と若年者の髄膜腫の4割くらいに素因がある
Pathmanaban ON, et al.: Association of Genetic Predisposition With Solitary Schwannoma or Meningioma in Children and Young Adults. JAMA Neurol. 2017
25歳未満(年齢中央値11歳)で髄膜腫が発見された患者さん42人のリンパ球をしらべて,髄膜腫になる素因をもともと持っていたのが16人 (38%) でした。NF-2遺伝子変異が40%,SMERCE1変異が14%であったとのことです。小児の髄膜腫の4割くらいの患者さんは,後々また髄膜腫や神経鞘腫を発生する可能性があるということです。
髄膜腫の発生原因
Clark VE, et al.: Recurrent somatic mutations in POLR2A define a distinct subset of meningiomas. Nature Genetics 48, 2016
Yale大学からの報告です。RNA polymerase IIというとても重要な遺伝子に異常があって髄膜腫が発生するという発表です。775例の髄膜腫を調べて,RNA polymerase IIをコードする POLR2Aに,recurrent somatic p.Gln403Lys or p.Leu438_His439del mutationsを発見したとのことです。この遺伝子がハイジャックされることで,髄膜の発生に関わるWNT6 and ZIC1/ZIC4の制御異常が生じます。既知のNF2, SMARCB1, TRAF7, KLF4, AKT1, PIK3CA, SMOに加えて,AKT3, PIK3R1, PRKAR1A, SUFUにも変異が認められるとの報告です。
髄膜腫が柔らかくて摘出しやすいか予想する
Yao A, et al.: Can MRI predict meningioma consistency?: a correlation with tumor pathology and systematic review. Neurosurg Rev 2016
脳外科医にとっては古くて大切な問題です。手術前にMRIで髄膜腫が柔らかくて摘出しやすいかどうかという課題を論じた報告です。結論的には単純で,T2強調画像で高信号(白く)見えるものは柔らかそうだということです。現行のMRI sequenceを駆使してもこれ以上のことはわからないということです。
髄膜腫の悪性度を客観的に決める方法
Duregon E, et al.: Better see to better agree: phosphohistone H3 increases interobserver agreement in mitotic count for meningioma grading and imposes new specific thresholds. Neuro Oncol 17: 663-963, 2015
髄膜腫の悪性度は核分裂の数 mitotic index で決められます。でもHE染色で分裂像がいくつあるかは病理医の悩みの種で数え方で大きく違いがでました。またMIB-1染色は正確には分裂像を見ているものではありません。Phosphohistone H3 (PHH3) serine-10は核分裂を数えるための特異抗体です。これを用いるとグレード1、2、3の髄膜腫が正確に分類できると期待されています。
髄膜腫の化学療法
Preusser M, Marosi C: Antiangiogenic treatment of meningiomas. Curr Treat Options Neurol 17:359, 2015
総論です。hydroxyurea, temozolomide, irinotecan, interferon-alpha, mifepristone, octreotide analogues, megestrol acetate, bevacizumab, sunitinib, vatalinib, imatinib, erlotinib, gefitinibという様々な抗がん剤が試されましたが有効性は確かめられませんでした。 腫瘍血管新生を抑制する力のある抗体,bevacizumab, sunitinib, vatalinibはある程度腫瘍の増殖抑制効果があるので確かめられるべきです。ヨーロッパのEORTCでtetra-hydroisoquinoline alkaloid trabectedinが試験段階です。AKT inhibitorsも分子診断で選択された例での試験があるようです。2015年時点でまだこれを使用すれば悪性髄膜腫が治るという薬剤は知られていないようです。
sunitinib化学療法
Kaley TJ, et al.: Phase II trial of sunitinib for recurrent and progressive atypical and anaplastic meningioma. Neuro Oncol 17:116-121, 2015
放射線治療も効かなかった30人のグレード2髄膜腫と6人のグレード3髄膜腫の患者さんがスニチニブで治療されました。42日周期で一日あたり50mgを28日間連続投与する方法です。6ヶ月無増悪生存割合は42%,無増悪生存期間中央値は5.2ヶ月,全生存期間中央値は24ヶ月でした。スニチニブは,a small-molecule tyrosine kinase inhibitor that targets vascular endothelial growth factor receptor and platelet-derived growth factor receptorですから,これらの腫瘍を治す力はありません。
発生の原因は
Andersen L, et al.: Hormone replacement therapy increases the risk of cranial meningioma. Eur J Cancer 2013 Jun 2
髄膜腫は成人女性に多い腫瘍ですから,以前から女性ホルモンと髄膜腫の発生の関連が疑われてきました。デンマークで,髄膜腫になった55歳から84歳の女性に対する,発症前の女性ホルモンの投与の有無が調査されました。924人が髄膜腫を有していました。女性ホルモンの投与を受けていると,髄膜腫の発生率は1.3倍に増加していました,10年以上投与されていると1.7倍になったそうです。エストロゲンとプロゲステロンの組み合わせの投与でより多い傾向がありました。でもだからといって,全ての更年期の女性へのホルモン補充が止められるわけではありません。まあそういうことかなというくらいです。
発生頻度は人口の1%に近い
Vernooij MW: Incidental findings on brain MRI in the general population. N Engl J Med. 2007
N Engl J Medという権威のある雑誌の報告です。Rotterdam Studyで2,000人のMRIが検索されました。母集団の平均年齢は63歳とやや高齢です。脳動脈瘤は1.8%,良性脳腫瘍は1.6%に発見されました。ほとんどが髄膜腫で人口の1%にあるとされます。
髄膜腫の治療学は学問か
Aghi M, Barker IF: Benign adult brain tumors: an evidence-based medicine review. Prog Neurol Surg 19: 80-96, 2006
ほとんど全ての成人良性脳腫瘍の研究は,質が低くて (レベル 3 かもっと低い),推奨度としてはグレード C だそうです。Randomized clinical trials are unlikely to occurと述べています。これは2006年のたいしたことない論文ですが,そのとおりで,今後も,経験学と多少の数を集めた研究成績を読み取って指標としていくしかありません。学会でのすばらしい成績発表もよくよく考えて受け取らなければなりません。
ガンマナイフか分割照射治療か
Matellus P, et al.: Evaluation of fractionated radiotherapy and gamma knife radiosurgery in cavernous sinus meningiomas: treatment strategy. Neurosurgery 57: 873-886, 2005
フランスのマルセイユの同一施設で分割照射とガンマナイフ治療の結果が検討された報告である。初発あるいは術後残存した海綿静脈洞髄膜腫の38例を分割照射で,36例を放射線外科(ガンマナイフ)で治療した。 追跡期間は前者で89ヶ月,後者で64ヶ月であった。広範な伸展範囲を有するものあるいはSekhar分類でのgrade III and IVは分割照射の群に多く,平均腫瘍体積は分割照射群で13.5 ml,ガンマナイフ群で5.2 ml であった。actuarial progression-free suvival (PFS)は,分割照射群で94.7%,ガンマナイフ群で94.4%であった。症状の改善率はほぼ同等であり,腫瘍縮小率は分割照射群で29%に対してガンマナイフ群で53%であった。有害事象は分割照射群の方が高率となっているがこれは照射容積の違いによるものが大きい。著者らは結論として,ガンマナイフ治療はより簡便であり腫瘍縮小率も高いので優先的に検討されるべきであり,分割照射はガンマナイフ治療が適さない症例で行なうべきであるとしている。
定位分割照射治療の有効性
Milker-Zabel S, et al.: Fractionated stereotactic radiotherapy in patients with benign or atypical intracranial meningioma: long-term experience and prognostic factors. Int J Radiat Oncol Biol Phys 61: 809-816,, 2005
1985-2001年に年齢中央値55.7歳,317人の髄膜腫患者を定位分割照射で治療した。target volume中央値は33.5mlであり,total dose中央値は57.6Gy (1.8Gy/day, 5 times/week)であった。5.7年の追跡機感中央値での腫瘍局所制御割合は93.1% (295/317)であった。22人(6.9%)で腫瘍増大が生じたがgrade IIの症例に多かったいうことである。また,60ml以上の体積の髄膜腫の再燃割合は15.5%であった。 有害事象としての神経症状の悪化は8.2%にみられ,視力の低下,三叉神経障害,耳鳴などであった。
悪性髄膜腫への定位放射線治療
Mattozo CA, et al.: Stereotactic radiation treatment for recurrent nonbenign meningiomas. J Neurusurg 106: 846-854, 2007
臨床的にも病理学的にも良性とはいえない髄膜腫に対する定位放射線治療の成績です。SRS(1回照射)とSRT(分割照射)が使われました。25人の患者さんで52個の髄膜腫が治療されました。治療中に8例(32%)でさらに悪性化が生じています。治療によって3年間増悪がなかったのはグレード1で100%とグレード2の11例で83%,グレード3の1例では無効でした。SRSのほうがSRTより無増悪生存期間が長かった傾向がありました。
ハイドレア化学療法
Neuton HB: Hydroxyurea chemotherapy in the treatment of meningiomas. Neurosurg Focus 23: 2007
単なる総論なのですが,2007年の段階でハイドロキシウレア(ハイドレア)の効果を論評したものです。この論評でも悪性の髄膜腫にはハイドレアが最も期待できる化学療法剤であろうと書かれています。ということは,他には有効そうな薬剤がないともとれます。ハイドレアによる化学療法は1900年代の半ばに注目されましたが,それ以来これといった進歩はありません。中には効く例もあるかもしれないというところが,ハイドレアの悪性髄膜腫に対する効果といえましょう。多数例での証明はありません。
文献
- Andersen L, et al.: Hormone replacement therapy increases the risk of cranial meningioma. Eur J Cancer 2013 Jun 2
- Duregon E, et al.: Better see to better agree: phosphohistone H3 increases interobserver agreement in mitotic count for meningioma grading and imposes new specific thresholds. Neuro Oncol 17: 663-963, 2015
- Kaley TJ, et al.: Phase II trial of sunitinib for recurrent and progressive atypical and anaplastic meningioma. Neuro Oncol 17:116-121, 2015
- Kshettry VR, et al.: Descriptive epidemiology of World Health Organization grades II and III intracranial meningiomas in the United States. Neuro Oncol 17:1166-1173, 2015
- Matellus P, et al.: Evaluation of fractionated radiotherapy and gamma knife radiosurgery in cavernous sinus meningiomas: treatment strategy. Neurosurgery 57: 873-886, 2005
- Mattozo CA, et al.: Stereotactic radiation treatment for recurrent nonbenign meningiomas. J Neurusurg 106: 846-854, 2007
- Milker-Zabel S, et al.: Fractionated stereotactic radiotherapy in patients with benign or atypical intracranial meningioma: long-term experience and prognostic factors. Int J Radiat Oncol Biol Phys 61: 809-816,, 2005
- Preusser M, Marosi C: Antiangiogenic treatment of meningiomas. Curr Treat Options Neurol 17:359, 2015
- Neuton HB: Hydroxyurea chemotherapy in the treatment of meningiomas. Neurosurg Focus 23: 2007
- Perry A, et al.: Malignancy in meningiomas: a clinicopathologic study of 116 patients, with grading implications. Cancer 85: 2046-2056, 1999
- Vernooij MW: Incidental findings on brain MRI in the general population. N Engl J Med. 2007
- Wang C, et al.: Overall survival benefit associated with adjuvant radiotherapy in WHO grade II meningioma. Neuro Oncol. 2017